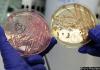
10 случаев кровавой диареи во Франции

отметили
22
человека
в архиве
Нефтяной пик и развал СССР: повторится ли кризис? Пиковое производство нефти поставило мир на грань глобальной катастрофы – вроде той, что произошла с СССР
 slon.ru
slon.ru
Принято считать, что причиной упадка Советского Союза стали неэффективность экономики и советская реакция на наращивание военной мощи администрацией Рейгана в начале 1980-х. Тем не менее, более вероятное объяснение заключается в падении производства нефти в СССР, вызванном пиковым производством нефт...
3 комментария
проблема (8)
отметили
27
человек
в архиве
Эксперты: опасная кишечная бактерия пришла в Европу из Африки
 vesti.ru
vesti.ru
Распространяющаяся в Германии кишечная инфекция более опасна, чем полагали ранее, речь уже может идти об эпидемии. Повышенная опасность кишечной палочки заключается в том, что вызывающая воспаление и кровотечение в кишечнике агрессивная бактерия из Центральной Африки каким-то образом соединилась с и...
отметили
72
человека
в архиве
Французским журналистам запретили без повода упоминать Facebook и Twitter в эфире habrahabr.ru
Французский Наблюдательный совет за электронными СМИ (Conseil Supérieur de l'Audiovisuel) запретил «необязательное» упоминание сервисов Facebook и Twitter в национальном теле- и радиоэфире. Речь идёт о словах телеведущего вроде «больше информации в нашем твиттере» или «ищите нас на Facebook» и други...
проблема (1)
отметили
87
человек
в архиве
Министр обороны США призвал Китай не брать пример с СССР и не начинать гонку вооружений
 inoforum.ru
inoforum.ru
После тирады о неуклонном усилении сил обороны КНР, Гейтс сменил тему заявив, что он «не верит в то, что Китай может бросить вызов вооружённым силам США в какой-либо области» и «я думаю, что Китай уже получил серьёзный урок на примере СССР, и не будет пытаться состязаться с нами по всему кругу (воор...
проблема (1)
отметили
7
человек
в архиве
Дания запустила в космос резиновую бабу
 seti-ceti.ru
seti-ceti.ru
Датские любители-астронавты успешно запустили в суборбитальный полет манекена. В следующий полет отправится живой человек.
проблема (7)
отметили
41
человек
в архиве
Знаменитый индийский йог объявил «голодовку до смерти», требуя казнить коррупционеров
 gazeta.ru
gazeta.ru
Свами Рамдев объявил голодовку, чтобы побудить государство принять более жесткие меры по борьбе с коррупцией.
Йог, ежедневную телепрограмму которого смотрят миллионы, начал голодовку после того, как кабинету министров не удалось убедить его отменить ее.
Свами Рамдев хочет, чтобы правительс...
проблема (1)
отметили
164
человека
в архиве
«Членовоз» опять сбил человека. Автомобиль губернатора иркутской области сбил пешехода на Ленинском проспекте
4 ru-vederko.livejournal.com
ru-vederko.livejournal.com
«Случилось все на моих глазах. „Герой“, непонятно зачем, нажал на газ прямо перед пешеходным переходом, в тот момент когда все машины остановились чтобы пропустить пешеходов. Номер не смог рассмотреть — ехал в маршрутке рядом с мигалкой в тот момент когда все случилось. Рядом с мужчиной которого сби...
проблема (1)
отметили
22
человека
в архиве
«Неприродное» происхождение «овощного гриппа»: биотерроризм или вирусный фарммаркетинг?
 rosbalt.ru
rosbalt.ru
«Практическое здравоохранение не может сейчас применять имеющиеся антибиотики для лечения этой инфекции, нужно другое поколение лекарств», — сказл Глава Роспотребнадзора
Так он прокомментировал публикации о вспышке инфекции, как акте биотерроризма.
«Неприродность есть в этом явлении. Она п...
проблема (2)
отметили
31
человек
в архиве
Крестьяне не встретились с президентом
 spravedlivo-online.ru
spravedlivo-online.ru
Сегодня, 3 июня делегация сельских жителей попыталась провести «крестьянский ход» за спасение российского села.Три основные проблемы в изложении одного из инициаторов «хода» Василия Мельниченко:
Первое – банкротство сельскохозяйственных предприятий. Тысячи квадратных километров буквально именем...
отметили
27
человек
в архиве
1 июня на Пушкинской площади в Москве прошел митинг в защиту образования.
 spravedlivo-online.ru
spravedlivo-online.ru
Главный лозунг — «Образование — право, а не услуга!».
Организаторы: Межрегиональный профсоюз работников образования «Учитель», Общественное Движение «Московские родители», Объединение «Российским детям — доступное дошкольное образование» (РДДДО), Инициативная группа сотрудников и студентов МГУ.
...
отметили
167
человек
в архиве
Сегодня — День Киллдозера
 ru.wikipedia.org
ru.wikipedia.org
Ма́рвин Джон Химе́йер (англ. Marvin John Heemeyer; 28 октября 1951 — 4 июня 2004) — сварщик, владелец мастерской в Грэнби, штат Колорадо. После длительного конфликта с компанией Mountain Park (цементный завод) по поводу территории, на которой находилась его мастерская, оборудовал бульдозер Komatsu D...
проблема (2)
отметили
16
человек
в архиве
Как ответственность делить будем, господа Щёголев и Яковлев? По закону или по понятиям? habrahabr.ru
Президент Медведев утвердил перечень поручений в сфере Интернета. Среди них подготовка предложений об установлении пределов ответственности за размещение комментариев читателей и высказываний третьих лиц.
Уважаемый Игорь Олегович, хочу изложить Вам, свои соображения об этой проблеме, а именно:
...
проблема (2)
отметили
30
человек
в архиве
НАТО впервые использовало в Ливии боевые вертолеты
 vesti.ru
vesti.ru
В ночь на 4 июня силы НАТО впервые применили в Ливии боевые вертолеты, сообщил командующий операцией канадский генерал Шарль Бушар. Удары наносились по боевой технике и военному имуществу войск, лояльных Муаммару Каддафи.
Два британских вертолета Apache, базирующиеся на борту вертолетоносца Oce...
проблема (2)
отметили
15
человек
в архиве
[Другой вгляд] «Мы — совершеннолетние дееспособные тетки, гражданки Российской Федерации..»
 mirrov-breath.livejournal.com
mirrov-breath.livejournal.com
Ее зовут Анна Анненкова, ей 31 год. Она финансовый аналитик по нефтегазу, у нее 3 законченных высших и четвертое – в процессе, она любит меня, хаус, биржевые графики, мед, Вайнону Райдер, слонов и жару, очень смешно чихает — и я ее люблю. Мы вместе 2 года. Познакомились, кстати, 28 мая – не на гей-п...
проблема (17)
отметили
10
человек
в архиве
В Хабаровске нашли кресло цесаревича, которому 120 лет
 habex.ru
habex.ru
Дежурная библиотекарь рассказала, что этому стулу 120 лет! Именно его собрали местные умельцы специально к приезду цесаревича, будущего императора Николая II
проблема (7)
отметили
40
человек
в архиве
Попытки Запада поднять в Ливии оппозицию провалились — экс-посол РФ
 rian.ru
rian.ru
Попытки Запада организовать и поднять в Ливии внутреннюю оппозицию против Муамара Каддафи провалились, считает советник ректора Дипломатической академии МИД РФ, бывший посол в этой североафриканской стране Олег Пересыпкин.
«В Ливии никогда не было системной оппозиции, и попытка НАТО поднять вну...
проблема (2)
отметили
86
человек
в архиве
Нижняя палата Конгресса потребовала от Обамы прояснить цели операции в Ливии
 vesti.ru
vesti.ru
Резолюцию, требующую от президента США Барака Обамы прояснить цели и роль страны в военной операции в Ливии, приняла в пятницу палата представителей Конгресса. В ее поддержку высказались 268 законодателей, против — 145. Инициатором резолюции стал спикер палаты представителей Джон Бейнер.
Данная за...
проблема (2)
отметили
14
человека
в архиве
Спецкоры Life News посетили брошенный жителями поселок Пугачево, в нескольких сотнях метрах от которого продолжают взрываться военные склады
 lifenews.ru
lifenews.ru
Пустующие улицы, по которым всего сутки назад ходили люди, легкие ветер носящий с места на место мусор, распахнутые окна и двери и висящий в воздухе сильнейший запах гари, — такая картина откроется каждому, кто рискнет заехать в эти часы в небольшой поселок Пугачево в республике Удмуртия.
Неско...
отметили
30
человек
в архиве
Вышел LibreOffice 3.4
 megabyte-web.ru
megabyte-web.ru
Пока OpenOffice.org в очередной раз меняет владельца и модель разработки, фонд The Document Foundation продолжает работу над форком популярного офисного пакета. Так, сегодня состоялся официальный релиз новой версии LibreOffice 3.4.0, включающей в себя изменения, предложенные 120 разработчиками.
...
проблема (1)
отметили
93
человека
в архиве
Госдума отказалась удалять Бога из российского гимна
 top.rbc.ru
top.rbc.ru
Госдума отклонила законопроект, предлагающий исключить из текста государственного российского гимна религиозные слова.
Автор проекта, депутат Госдумы от КПРФ Борис Кашин требовал убрать из гимна слова «хранимая Богом родная земля» и заменить их на «хранимая нами родная земля».
Как указал в...
отметили
40
человек
в архиве
«Облачная демократия» — технологии дают нам возможности вернуться к механизмам прямой демократии, от которых мы давно отказались
 cdem.ru
cdem.ru
Новые технологии изменили мир бизнеса и отношений между людьми и рвутся в затхлый мир политики. Это особенно актуально для нынешней России: граждане нашей страны активно используют все технологические возможности современности, при этом оставаясь заложниками архаичной в самой своей сути политической...
отметили
6
человек
в архиве
отметили
45
человек
в архиве
Бульвар для бомжей. Любимые места москвичей превратились в помойку
 mk.ru
mk.ru
Это, конечно, произошло не за один день и даже не за один год. Накапливалось незаметно — по одной брошенной пустой бутылке, по одному заснувшему на лавочке бомжу. И как всегда резко и неожиданно количество перешло в качество. Теперь остается только разводить руками — ряд бульваров Москвы, украшение ...
отметили
25
человек
в архиве
США испытают в Афганистане новую активную защиту
 lenta.ru
lenta.ru
Управление перспективных исследовательских проектов (DARPA) совместно с войсками быстрого оснащения Армии США в конце 2011-го — начале 2012 года начнет испытания в Афганистане новой системы активной защиты легких бронемашин Iron Curtain (IC-APS). Как сообщает Aviation Week, в полевых испытаниях прим...
отметили
47
человек
в архиве
Мосгорсуд начал обнародовать официальные письма с попыткой давления на судей
 rg.ru
rg.ru
Московский городской суд ввел новую практику: официальные письма из высоких инстанций по конкретным делам теперь будут предаваться гласности.
На сайте столичного суда появилась новая страничка, где уже опубликованы первые вип-обращения, некоторые фамилии подписавшихся известны всей стране.
...
проблема (1)
отметили
19
человек
в архиве
Петербургские депутаты лоббируют увеличение штрафов за несанкционированную установку кондиционеров на фасадах зданий.
 fontanka.ru
fontanka.ru
31 мая депутаты петербургского ЗакСа в первом чтении приняли поправки к закону «Об административных правонарушениях» — теперь за самовольную установку дополнительных элементов фасада физическим лицам придется выплатить 5 тысяч рублей вместо двух, а юридическим — пятьсот тысяч вместо двадцати. Но не ...
отметили
11
человек
в архиве
10 случаев кровавой диареи во Франции
 zman.com
zman.com
С начала эпидемии, вызванной бактерией E.coli, во Франции зарегистрировано 10 случаев кровавой диареи и все у людей, вернувшихся из Германии. Об этом сообщает французский Институт санитарной безопасности.
Речь идет о взрослых в возрасте от 16 до 55 лет и одном подростке 14 лет. Одна из заболев...
проблема (2)
отметили
27
человек
в архиве
Сбитый БМВ министра финансов Алексея Кудрина бомж считает, что сам виноват в ДТП. Интервью о жестокой жизни в Москве
 lifenews.ru
lifenews.ru
В Москву Кураев приехал 6 мая из Пензенской области – на заработки.
— Я послушал друзей, они здесь зарабатывают неплохие деньги, — рассказывает Сергей, теребя крестик под рубашкой. – Тем более что они сами меня позвали работать на объект, сказали, что я хороший специалист и здесь не пропаду.
...
отметили
16
человек
в архиве
Куда уйдет золото арабских диктаторов
 rbcdaily.ru
rbcdaily.ru
Когда в начале мая Швейцария заморозила банковские счета Муамара Каддафи, Зин аль-Абидина бен Али и Хосни Мубарака, эта новость осталась почти незамеченной. За последние месяцы арабских революций подобные известия приходили из разных стран, но самый богатый урожай обеспечил ливийский полковник: нало...
проблема (3)
отметили
20
человек
в архиве
В США умер «Доктор Смерть»
 lenta.ru
lenta.ru
Бывший врач Джек Кеворкян, известный под прозвищем «доктор Смерть», скончался в американской больнице William Beaumont, расположенной в пригороде Детройта, штат Мичиган утром в пятницу, 3 июня. Об этом сообщает ClickOnDetroit.сom.
Причиной смерти Кеворкяна врачи назвали тромбоз легочной артерии. В...
проблема (2)













![[Другой вгляд] «Мы — совершеннолетние дееспособные тетки, гражданки Российской Федерации..»](/story_images/310000/1307173349_50_generated.jpg)